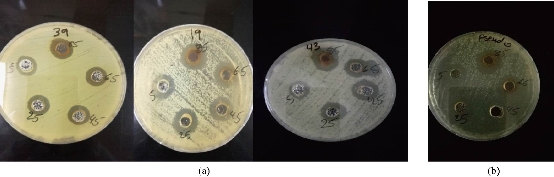
D:\xwu\Nano Biomedicine and Engineering\Articles for production\排版\2019\11(3)\8. NBE-2018-0094 已排版 代校订_20190910\297-305\soht6.jpg
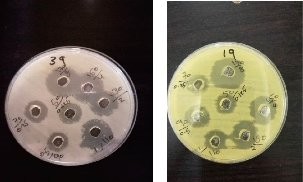
D:\xwu\Nano Biomedicine and Engineering\Articles for production\排版\2019\11(3)\8. NBE-2018-0094 已排版 代校订_20190910\297-305\soht8.jpg

Research Article
Silver Nanoparticles as an Effective Anti-Nanobacterial System towards Biofilm Forming Pseudomonas oryzihabitans
Shaimaa Obaid Hasson 1*, Mohammed Jabber Al-Awady 2, Mohanad Jawad Kadhim 2, Hayder Shkhair Al-Janabi 2
1 Department of Microbiology, College of Veterinary, Al-Qasim Green University, Babylon, Iraq.
2 Department of Genetic Engineering, Faculty of Biotechnology, Al Qasim Green University, Babylon, Iraq.
* Corresponding author. E-mail: shaimaaobead@gmail.com
Received: Jun. 18, 2019; Accepted: Aug. 22, 2019; Published: Aug. 23, 2019
Citation: Shaimaa Obaid Hasson, Mohammed Jabber Al-Awady, Mohanad Jawad Kadhim, and Hayder Shkhair Al-Janabi, Silver Nanoparticles as an Effective Anti-Nanobacterial System towards Biofilm Forming Pseudomonas oryzihabitans. Nano Biomed. Eng., 2019, 11(3): 297-305.
DOI: 10.5101/nbe.v11i3.p297-305.
Abstract
Silver nanoparticles have been considered a powerful antimicrobial agents recently especially after increasing incidence of diseases associated with biofilm and multi-drug resistant pathogens required to find a novel path to eradicate that challenge. The present study aims to evaluate the antibacterial activity of biosynthesized silver nanoparticles (AgNPs) using a cell-free extract of Enterobacter cloacae and chemo synthesis by sodium borohydride (NaBH4) on biofilm-forming Pseudomonas oryzihabitans. Antimicrobial effect of silver nanoparticles in both types and in combination with imipenem were evaluated by agar well diffusion method. The results revealed a good response to inhibit biofilm-forming Pseudomonas oryzihabitans growth by silver nanoparticles antibacterial activity in both types (biological and chemical) and in combination with imipenem; the antimicrobial effect was increased and enhanced. In the present study, it was found that the biological and chemical silver nanoparticles were considered a novel and decisive solution against biofilm and multi- drug resistance bacteria with a preference of biological silver nanoparticles.
Keywords: Biological silver NPs; Chemical silver NPs; Biofilm; Pseudomonas oryzihabitans; Imipenem
Introduction
Silver-ions have been reported to possess strong biocidal effects [1]. The silver-compounds are used as disinfection agents from the ancient time [2]. Nanoparticles have dimension less than 100 nm [3]. Silver nanoparticles (AgNPs) contain compounds which act as antimicrobial agents [4]. Recently, silver nanoparticles have been considered as powerful antimicrobial agents, especially with increasing incidence of diseases associated with biofilm and multi-drug resistance pathogens which are necessarily required to find a novel path to eradicate that challenge. Moreover, there are wide range of studies focusing on AgNPs antimicrobial activity [5]. They possess a high activity against microorganisms (bacteria, fungi, and virus) but the mechanism of action still mostly unknown [6]. Silver has long standing antibacterial compound, and silver nanoparticles are more potent in antimicrobial effect than normal scale [7, 8]. Silver nanoparticles increase bacterial susceptibility to antibiotics when combined with them as synergistic effect especially in biofilm infection [9], for example, nitrofurazone increased its effect in silver present [10]. Studies have pointed out that silver is non-toxic, safe, and may not accumulate or cause harmful effects to human body, so silver nanoparticles have been used in the medical field as wound dressing, heart valves and face mask [11]. Many methods such as chemical and biological methods have been used to synthesize silver nanoparticles [12]. Most researchers tend to use the biological method because it is eco-friendly, inexpensive and more antimicrobial-effective than other methods. Many microorganisms like bacteria [13, 14] can produce nanoparticles through two routes; intracellular and extracellular [3, 15]. The intracellular route deals with mixing the filtrate of the bacterial cell with metal salt then kept in a shaker incubator in dark condition [16]. And on the other hand, the extracellular route relies on using bacterial supernatant after centrifuging at 8000 rpm then mixing with metal salt, and incubating in dark condition [17]. In principle, the microorganism can synthesize nanoparticles by redoxing enzymes which are produced by bacterial activities, then act as electron shuttle to snatch the target ions from its environment to reduce the metal ions to nanoparticles [3, 18], which lead to precipitate the product nanoparticles on cell external environment [18]. In biological synthesis method, the protein responsible for ion reduction is found to secret at a large amount [19]. The chemical method used in nanoparticles synthesis is the chemical reduction, which reduces the metal ions to nano-sized particles by reduction agents such as sodium citrate, sodium borohydride, elemental hydrogen, ascorbate, etc. [20, 21]. Biofilm is aggregation of bacterial communities embedded in exopolysaccharide matrix (EPS). Bacteria within biofilm communication tend to resist antibiotics and avoid a host immune system. The EPS protects biofilm bacteria from antibiotics action by shielding it [22]. Based on the emergence of pathogenic bacterial strains, especially biofilm-forming bacteria have ability to develop antibiotics resistant to be multi-drug resistant bacteria. The medical world is in urgent need of a new way to eradicate and kill biofilm-forming bacteria. AgNPs are the most promising antimicrobial agents to fill this role [23-25]. The present study aims to evaluate the antibacterial activity of biosynthesized AgNPs using a cell-free extract of Enterobacter cloacae and chemo synthesis by NaBH4 (sodium borohydride) on biofilm-forming Pseudomonas oryzihabitans.
Experimental
Bacterial isolates
Biofilm-forming bacterial isolates (P. oryzihabitans) were isolated and identified according to previous study [26].
Preparation and characterization of silver nanoparticles
The chemical method for the preparation of silver nanoparticles was carried out according to the procedure described by Hasson et al. [9] with some modifications. Briefly, silver nanoparticles were synthesized chemically using sodium borohydride as reducing agent and silver nitrate (AgNO3) as a precursor (5 mL of 0.01 M AgNO3 was added dropwise (1 drop per sec.) to 50 mL of 0.001M NaBH4). On the other hand, the biosynthesis of silver nanoparticles was accomplished by using supernatant free Enterobacter cloacae as reducing agents with aliquot of silver nanoparticles: 0.25 mL of 0.1 M AgNO3 was added to 50 mL of 10 mL bacterial supernatant (E. cloacae) and 40 mL deionized water. To calculate the final concentrations of nanoparticles’ production in both types, the following steps were followed: Final concentration (con.) of chemosynthesis AgNPs: N1V1=N2V2, N1 × 50=0.01 × 5 = 0.001. Then, final con. = N1 × MW of AgNO3 × 1000, 0.001 × 170 × 1000 = 170 µg/mL. And the biological synthesis was: N1V1 = N2V2 = N1 × 50 = 0.1 × 0.25 = 0.0005 M. Then, final con. = N1 × MW of AgNO3 × 1000 = 0.0005 × 170 × 1000 = 85 µg/mL. The AgNPs for both methods were characterized using ultraviolet–visible spectroscopy (UV-Vis), Fourier-transform infrared spectroscopy (FTIR), particle size distribution and zeta potential as mentioned by Al-Azawi et al. and Hasson et al. [27, 28].
Antimicrobial susceptibility assay of silver nanoparticles
Antimicrobial activity of the bio- and chemo-synthesized AgNPs was evaluated using the agar well diffusion method. This method was carried out according to CLSI [29] by preparing biofilm-forming P. oryzihabitans inoculum at turbidity equivalent to McFarland tube standard at 1.5 × 108 CFU/mL, then seeded by streaking method on Muller Hinton agar plate and then waited for 10 min to dry. Afterwards, 5 wells were made by cork borer at 8 mm and each filled with 100 µL from either chemically synthesized AgNPs solution at different concentrations (170, 150, 130, 110 and 90 µg/mL) or biologically synthesized AgNPs with different concentrations (85, 65, 45, 25 and 5 µg/mL). All plates were incubated at 37 °C for 24 h, with dark conditions. Both AgNPs types were diluent by deionized water [30]. After incubation, the inhibition zone diameter was measured by ruler to nearest whole millimeter. The results of both types were compared with related bacterial reference strains as control.
Combination of chemo- and bio-synthesized AgNPs with the antibiotic
The test was carried out according to Verma [31] using well diffusion agar to determine the antibacterial effect of AgNPs (chemical and biological) in combination with imipenem. As mentioned above about streaking biofilm-forming P. oryzihabitans on Muller Hinton agar, many wells were made by cork borer and each well contained 100 µL from both (50 µL from each one): Imipenem concentration at 8, 4, 2, 1, 0.5, 0.25 and 0.125 µg/mL (antibiotic con. according to CLSI, 2017 MIC values [29]) with chemical AgNPs concentration at 170, 150, 130, 110, 90, 70 and 50 µg/mL to be 170/8, 150/4, 130/2, 110/1, 90/0.5, 70/0.25 and 50/0.125, and with biological AgNPs concentration at 85, 65, 45, 25 and 5 µg/mL to be 85/8, 65/4. 45/2. 25/1 and 5/0.5. All plates were incubated at 37 °C for 24 h, with dark conditions. After incubation time, the inhibition zone diameter was measured by ruler to nearest whole millimeter. The synergistic effect was calculated according to equation [31]: Synergistic effect = [(B-A)/A] × 100, where A = zone of inhibition (ZOI) for antibiotic and B = ZOI for antibiotics + Ag-NPs
Statistical analysis:
Statistical analysis was done by using t-test and one way ANOVA at p-value 0.05 by SPSS Statistics 24.0 software.
Results and Discussion
AgNPs were considered effective against bacteria resistant to antibiotics, as well as against fungi and viruses [2]. The chemical synthesis of AgNPs was accomplished by using NaBH4 as reducing agent which reduces silver nitrate to AgNPs [32], while the biological synthesis method is simple and low-cost approach for the preparation of stable AgNPs by reduction of silver nitrate solution using supernatant free Enterobacter cloacae as a result of the presence of nitrate reductase enzyme. Nitrate reductase in bacteria is the main enzyme concerning silver nanoparticles synthesis [33]. The reduction of this enzyme functions as an NADPH dependent nitrate reductase metal ion (Ag+ ions) to synthesize nanoparticles (silver NPs). The enzyme acts to convert the nitrate to nitrite [34], and then shuttles the electron to silver ions [20]. The characterization of the produced AgNPs was conducted in two ways as follows:
Visual inspection
The visual inspection of the produced chemical and biological AgNPs revealed dark brown or brown instead of colorless AgNO3 (Fig. 1(a) and(b)), and that change in color occurred after adding reduction agents (NaBH4 or bacterial supernatant) related to reduction indicator to convert Ag+ to Ag0 to be nanoparticles. In chemical AgNPs, the color increased in degree to be dark brown when continuing mixing with magnetic stirrer for 0.5 h. In biological AgNPs, change in the color was previously reported in many extracellular synthesis methods from bacterial source [35] and from Enterobacter cloacae especially [13]. The brown color in both methods is related to the excitation of AgNPs surface Plasmon vibration [36] as a result of AgNPs production.
Ultraviolet-visible spectroscopy (UV-Vis)
The observation of biological AgNPs synthesized by E. cloacae was strong with narrow surface peak reaching to 400 nm (Fig. 1(c)). Narrow peak indicates narrow size range of nanoparticles less than100 nm [13]. Yes in chemical AgNPs, UV-visible absorption spectrophotometer revealed the absorption band was at 390 nm (Fig. 1(c)) due to AgNPs Plasmon resonance. The absorption energy of AgNPs depends on Plasmon resonance degree which represents the ratio of silver ion to silver zero valent [32]. UV-visible absorption spectra of AgNPs were due to surface plasmon resonance absorption because of the vibration combination of AgNPs free electrons with light wave, and also it was considered as another indicator of nanoparticles production at the range of absorption from 390-420 nm [37].

Fig. 1 (a) Color profile for the synthesized silver NPs using chemical method through reduction of silver ions with sodium borohydride as a reducing agent. (b) Color profile for the biosynthesized silver NPs using secondary metabolites of bacteria. (c) UV-visible absorption spectrum of chemically and biologically synthesized silver nanoparticles.
Size analyzer
The AgNPs size of both methods was determined by dynamic light scattering. The nanoparticle distribution analysis of chemically synthesized AgNps revealed the average particle size was approximately 22-28 nm (25 ± 3) (Fig. 2(a)), while the size of biosynthesized AgNPs was 56-70 nm (63 ± 7) (Fig. 2(b)). The antibacterial activity of AgNPs bears the influence of the particle size. Small particles are well known to be more effective than large ones in terms of antibacterial and antibiofilm performance [38]. Many previous studies reported that antibacterial activity was based on the particle size of AgNPs [39]. The size of nanoparticles has a crucial role in the field of biomedicine. In blood stream, the size regulates navigation and circulation of NPs. In addition, to affect penetration the drug across the physiological barriers, localization on specific site and cellular responses induction [40, 41].

Fig. 2 (a) Average particle diameter of chemo-synthesized AgNPs. (b) Average particle diameter of biosynthesized AgNPs.
Antimicrobial effects of AgNPs on biofilm bacteria
Antimicrobial activity of the chemo- and bio-synthesized AgNPs was evaluated using the agar well diffusion method on biofilm-forming P. oryzihabitans.
Agar well diffusion method
The test was conducted on biological and chemical AgNPs in different concentrations to biofilm P. oryzihabitans and the control. AgNPs inhibit biofilm formation of P. oryzihabitans [2]. The results revealed that AgNPs’ antibacterial activity increased with its concentration rising in both types (chemical and biological AgNPs) (Fig. 3-6), which was close to our previous results [9]. The statistical analysis showed that there was a significant difference among biofilm activity of P. oryzihabitans isolates of chemical AgNPs with p = 0.03 (Table 1), while there was no significant difference among isolates in biological AgNPs’ activity with p = 0.734 (Table 2). Recently, other researchers developed chip technique which revealed that AgNPs were able to eradicate P. aeruginosa biofilms completely when treated at 0.5 ug/mL [22]. The antibacterial effect of AgNPs is an electrostatic interaction between nanoparticles and bacterial cell membrane to disrupt it by modified membrane morphology to increase its permeability, which converts the bacterial cell enable to regulate transport mechanism leading to cell death [42, 43]. In addition to producing free radicals (ROS) which prompted the damage of a cell membrane, the inhibiting function of protein and destruction of DNA result in excess free radical production [43]. The destabilization of a cell membrane and reduction of adenosine triphosphate (ATP) level in bacterial cell can kill it [44]. Thus, AgNPs are considered a broad-spectrum antibacterial agent [45]. AgNPs also interact strongly with thiol group, leading to destructing the vital enzyme, also binding to thiol and amino group to disrupt protein synthesis in the cell wall and causing loss of DNA by inhibiting its replication [46, 47]. It occurs when AgNPs destruct cell wall permeability and then could invade bacterial cell into cytoplasm and interact with DNA to avoid the replication process which leads to cell death [48]. Moreover, several authors reported that AgNPs inclined to accumulate at the bacterial membrane, and diminution integrity of the bacterial membrane, which led to cellular death [42, 49]. Biological AgNPs seemingly were more effective against biofilm P. oryzihabitans than chemical AgNPs, but statistical analysis showed no significant difference between them with p = 0.420 (Table 3).

Fig. 3 Zone of growth inhibition (mm) of chemical AgNPs against biofilm P. oryzihabitans and P. aeruginosa as control.

Fig. 4 Antibacterial activity of chemical AgNPs on biofilm P. oryzihabitans isolates: (a) P. oryzihabitans 3 isolates; (b) non-biofilm P. aeruginosa as control.
Table 1 Statistical analysis of antibacterial effect of chemical AgNPs on biofilm P. oryzihabitans isolates
|
AgNPs con. (µg/mL) |
Zone of inhibition (mean ± SE) |
p-value |
|
170 |
21.0000 ± 1.73205 |
0.03 |
|
150 |
16.0000 ± 0.91287 |
|
|
130 |
15.2500 ± 0.94648 |
|
|
110 |
14.7500 ± 0.75000 |
|
|
90 |
13.0000 ± 1.35401 |

Fig. 5 Zone of growth inhibition (mm) of biological AgNPs against biofilm P. oryzihabitans and P. aeruginosa as control.
Fig. 6 Antibacterial activity of biological AgNPs on biofilm P. oryzihabitans isolates: (a) P. oryzihabitans 3 isolates; (b) non-biofilm P. aeruginosa as control.
Table 2 Statistical analysis of antibacterial effect of biological AgNPs on biofilm P. oryzihabitans isolates
|
AgNPs con. (µg/mL) |
Zone of inhibition (Mean ± SE) |
p-value |
|
85 |
15.7500 ± 1.43614 |
0.734 |
|
65 |
14.5000 ± 0.86603 |
|
|
45 |
16.2500 ± 2.92617 |
|
|
25 |
16.0000 ± 3.00000 |
|
|
5 |
12.7500 ± 0.75000 |
Table 3 Statistical analysis (t-test) of antibacterial effect of AgNPs in both types on biofilm P. oryzihabitans isolates
|
AgNPs type |
Zone of inhibition (Mean ± SE) |
p-value |
|
Biological |
16.000 ± 0.777 |
0.420 |
|
Chemical |
15.000 ± 0.865 |
Combination both types of AgNPs with imipenem
From the previous study [26], it was found that imipenem antibiotic was the most effective antibiotic on biofilm P. oryzihabitans. To study the synergism effect between AgNPs in both types and imipenem, the combination with each other was carried out.
Combination chemical AgNPs with imipenem
The results showed that antibacterial activity of AgNPs in two types of combination with imipenem was increased and enhanced on inhibiting the growth of biofilm P. oryzihabitans (Fig. 7-10). The statistical analysis showed that a significant difference existed between P. oryzihabitans growth inhibition and concentration value of both types of AgNPs in combination with imipenem at p < 0.01 (Table 4 and 5). The antibacterial effect of the combination of AgNPs and antibiotic exhibited higher effect than AgNPs or antibiotic alone, which corresponded to other studies [37, 50]. Furthermore, researchers pointed out that combined antibiotics with AgNPs brought about greater anti-biofilm activity and elevated bacterial cell death level, and so treatment with combination of antibiotics and AgNPs is considered of more potent effectiveness in terms of antibacterial and ant-biofilm performance. Statistical analysis discovered that biological AgNPs in combination with imipenem were more effective than chemical AgNPs with imipenem, with a significant differences at p = 0.05 (Table 6). Results of the combination of AgNPs in two types with imipenem revealed synergistic effect against biofilm P. oryzihabitans. Table 7 and 8 show a highly synergistic effect and antibacterial activity mostly more than each one alone of both types (chemical and biological) of AgNPs to biofilm P. oryzihabitans. Antibacterial activity of AgNPs in other studies increased to reach 70% to gram-negative biofilm-forming bacteria when combined with ampicillin [37]. In addition, bacterial susceptibility to antibiotics increased when combined with them as synergistic effect; especially in biofilm infection like nitrofurazone, the effect increased in the presence of silver [10].

Fig. 7 Antibacterial effect of the combination of imipenem and chemical AgNPs on biofilm-forming P. oryzihabitans.
Fig. 8 Antibacterial effect of the combination of imipenem and chemical AgNPs (in different con. (µg/mL)) on biofilm-forming P. oryzihabitans.
Table 4 Statistical analysis of antibacterial effect of the combination of chemical AgNPs with imipenem on biofilm P. oryzihabitans isolates
|
AgNPs / imipenem con. (µg/mL) |
Zone of inhibition (mean ± SE) |
p-value |
|
170/8 |
24.0000 ± 0.00000 |
< 0.01 |
|
150/4 |
21.0000 ± 0.00000 |
|
|
130/2 |
16.3333 ± 0.33333 |
|
|
110/1 |
17.6667 ± 0.88192 |
|
|
90/0.5 |
13.6667 ± 0.33333 |
|
|
70/0.25 |
13.3333 ± 0.33333 |
|
|
50/0.125 |
13.3333 ± 0.33333 |

Fig. 9 Antibacterial effect of the combination of imipenem and biological AgNPs on biofilm-forming P. oryzihabitans.

Fig. 10 Antibacterial effect of the combination of imipenem and biological AgNPs (in different con. (µg/mL)) on biofilm-forming P. oryzihabitans.
Table 5 Statistical analysis of antibacterial effect of the combination of biological AgNPs with imipenem on biofilm P. oryzihabitans isolates
|
AgNPs / imipenem conc. (µg/mL) |
Zone of inhibition (mean ± SE) |
p-value |
|
85/8 |
26.6667 ± 0.333 |
< 0.01 |
|
65/4 |
25.3333 ± 0.333 |
|
|
45/2 |
23.3333 ± 0.333 |
|
|
25/1 |
19.6667 ± 0.333 |
|
|
5/0.5 |
13.6667 ± 0.333 |
Table 6 Statistical analysis (t-test) of antibacterial effect of the combination of both AgNPs with imipenem on biofilm P. oryzihabitans isolates
|
AgNPs type |
Zone of inhibition (mean ± SE) |
p-value |
|
Biological with imipenem |
21.733 ± 1.255 |
0.05 |
|
Chemical with imipenem |
17.047 ± 0.871 |
Table 7 Synergism effect (%) between chemical AgNPs and imipenem on biofilm P. oryzihabitans isolates
|
Con. |
P. oryzihabitans 1 |
P. oryzihabitans 2 |
P. oryzihabitans 3 |
|
170/8 |
0 |
9 |
9 |
|
150/4 |
50 |
40 |
16 |
|
130/2 |
14.2 |
21.4 |
6.6 |
|
110/1 |
35.7 |
28.5 |
14.2 |
|
90/0.5 |
18 |
16.6 |
16.6 |
Table 8 Synergistic effect (%) between biological AgNPs and imipenem on biofilm P. oryzihabitans isolates
|
Con. |
P. oryzihabitans 1 |
P. oryzihabitans 2 |
P. oryzihabitans 3 |
|
85/8 |
92.8 |
80 |
71.4 |
|
65/4 |
100 |
85.7 |
78.5 |
|
45/2 |
71.4 |
76.6 |
76.9 |
|
25/1 |
53.8 |
53.8 |
46.1 |
|
5/0.5 |
8.3 |
16.6 |
16.6 |
Conclusions
In this study, the biological and chemical silver nanoparticles were considered a novel and decisive solution against biofilm and multi-drug resistant bacteria with a preference of biological silver nanoparticles. Also, the antibacterial effect of combining both types of AgNPs and imipenem exhibited a higher synergistic effect than AgNPs or antibiotic alone at a significant value.
Conflict of Interests
The authors declare that no competing interest exists.
References
Copyright© Shaimaa Obaid Hasson, Mohammed Jabber Al-Awady, Mohanad Jawad Kadhim, and Hayder Shkhair Al-Janabi. This is an open-access article distributed under the terms of the Creative Commons Attribution License, which permits unrestricted use, distribution, and reproduction in any medium, provided the original author and source are credited.